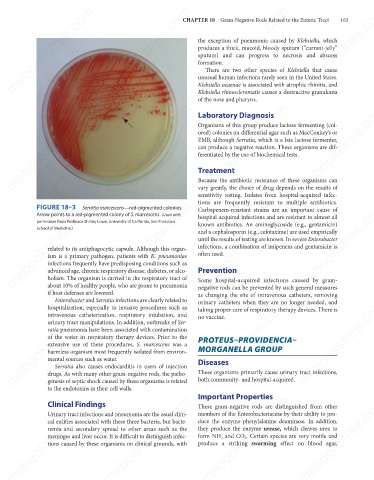

Page 174 - Review of Medical Microbiology and Immunology ( PDFDrive )
P. 174
mebooksfree.com
mebooksfree.com
mebooksfree.com
mebooksfree.com
mebooksfree.com
mebooksfree.com
mebooksfree.com
mebooksfree.com
mebooksfree.com mebooksfree.com mebooksfree.com CHAPTER 18 Gram-Negative Rods Related to the Enteric Tract 163 mebooksfree.com
the exception of pneumonia caused by Klebsiella, which
produces a thick, mucoid, bloody sputum (“currant-jelly”
sputum) and can progress to necrosis and abscess
formation.
There are two other species of Klebsiella that cause
unusual human infections rarely seen in the United States.
Klebsiella ozaenae is associated with atrophic rhinitis, and
Klebsiella rhinoscleromatis causes a destructive granuloma
of the nose and pharynx.
mebooksfree.com
mebooksfree.com mebooksfree.com mebooksfree.com Organisms of this group produce lactose-fermenting (col- mebooksfree.com
mebooksfree.com
Laboratory Diagnosis
ored) colonies on differential agar such as MacConkey’s or
EMB, although Serratia, which is a late lactose fermenter,
can produce a negative reaction. These organisms are dif-
ferentiated by the use of biochemical tests.
Treatment
Because the antibiotic resistance of these organisms can
vary greatly, the choice of drug depends on the results of
sensitivity testing. Isolates from hospital-acquired infec-
tions are frequently resistant to multiple antibiotics.
mebooksfree.com
mebooksfree.com
mebooksfree.com mebooksfree.com mebooksfree.com known antibiotics. An aminoglycoside (e.g., gentamicin) mebooksfree.com
FIGURE 18–3
Serratia marcescens—red-pigmented colonies.
Carbapenem-resistant strains are an important cause of
Arrow points to a red-pigmented colony of S. marcescens. (Used with
hospital-acquired infections and are resistant to almost all
permission from Professor Shirley Lowe, University of California, San Francisco
School of Medicine.)
and a cephalosporin (e.g., cefotaxime) are used empirically
until the results of testing are known. In severe Enterobacter
infections, a combination of imipenem and gentamicin is
related to its antiphagocytic capsule. Although this organ-
often used.
ism is a primary pathogen, patients with K. pneumoniae
infections frequently have predisposing conditions such as
Prevention
advanced age, chronic respiratory disease, diabetes, or alco-
holism. The organism is carried in the respiratory tract of
about 10% of healthy people, who are prone to pneumonia
negative rods can be prevented by such general measures
if host defenses are lowered. Some hospital-acquired infections caused by gram-
as changing the site of intravenous catheters, removing
Enterobacter and Serratia infections are clearly related to
mebooksfree.com mebooksfree.com mebooksfree.com PROTEUS–PROVIDENCIA– mebooksfree.com mebooksfree.com
mebooksfree.com
urinary catheters when they are no longer needed, and
hospitalization, especially to invasive procedures such as
taking proper care of respiratory therapy devices. There is
intravenous catheterization, respiratory intubation, and
no vaccine.
urinary tract manipulations. In addition, outbreaks of Ser-
ratia pneumonia have been associated with contamination
of the water in respiratory therapy devices. Prior to the
extensive use of these procedures, S. marcescens was a
MORGANELLA GROUP
harmless organism most frequently isolated from environ-
mental sources such as water.
Diseases
Serratia also causes endocarditis in users of injection
These organisms primarily cause urinary tract infections,
drugs. As with many other gram-negative rods, the patho-
both community- and hospital-acquired.
genesis of septic shock caused by these organisms is related
to the endotoxins in their cell walls.
mebooksfree.com mebooksfree.com mebooksfree.com Important Properties mebooksfree.com mebooksfree.com
mebooksfree.com
Clinical Findings
These gram-negative rods are distinguished from other
members of the Enterobacteriaceae by their ability to pro-
Urinary tract infections and pneumonia are the usual clini-
duce the enzyme phenylalanine deaminase. In addition,
cal entities associated with these three bacteria, but bacte-
they produce the enzyme urease, which cleaves urea to
remia and secondary spread to other areas such as the
form NH and CO . Certain species are very motile and
meninges and liver occur. It is difficult to distinguish infec-
3
2
produce a striking swarming effect on blood agar,
tions caused by these organisms on clinical grounds, with
mebooksfree.com mebooksfree.com mebooksfree.com mebooksfree.com mebooksfree.com mebooksfree.com